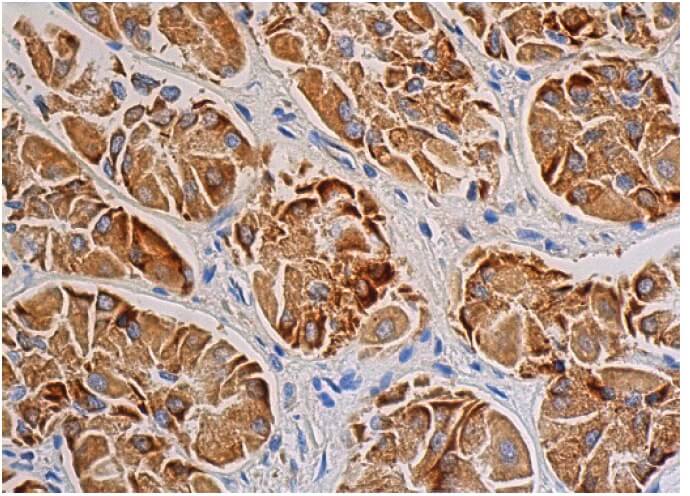
ERK 1 Antibody (G-8) | SCBT - Santa Cruz Biotechnology

マイストア
変更
お店で受け取る
(送料無料)
配送する
納期目安:
2026.04.17 11:47頃のお届け予定です。
決済方法が、クレジット、代金引換の場合に限ります。その他の決済方法の場合はこちらをご確認ください。
※土・日・祝日の注文の場合や在庫状況によって、商品のお届けにお時間をいただく場合がございます。
erk様限定 ERK 1 Antibody (G-8) | SCBT - Santa Cruz Biotechnologyの詳細情報
ERK 1 Antibody (G-8) | SCBT - Santa Cruz Biotechnology。ゼクストリーム 2024.WINTER | Z/X -Zillions of enemy X-。DIRKEI様 リクエスト 9点 まとめ商品。ホワイトセラミックのJ12モデル、アナログダイヤル、防水機能付き。。K-2プロジェクト ZX-14R(KAWASAKI ZX-14R) | ヘリテイジ&レジェンズ。- ブランド: CHANEL- モデル名: J12- カラー: ホワイト- 素材: セラミック- 特徴: 防水機能- ダイヤルタイプ: アナログご覧いただきありがとうございます。クレイジーベア 腕時計
ベストセラーランキングです
近くの売り場の商品
カスタマーレビュー
オススメ度 4.2点
現在、4692件のレビューが投稿されています。

![最終値引 [美品・訳あり] GRETSCH G9500 Jim Dandy](https://static.mercdn.net/item/detail/orig/photos/m28635178558_1.jpg)


